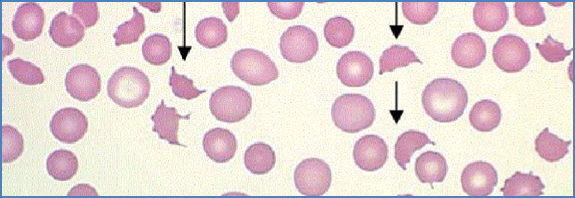
Warm Antibody Autoimmune Haemolytic Anaemia
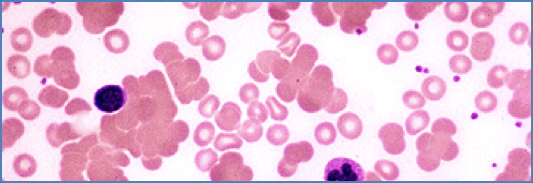
Cold Antibody Autoimmune Haemolytic Anaemia

Table of Contents
Overview – Anaemia
Anaemia refers to a decrease in haemoglobin concentration, impairing oxygen transport to tissues. It is one of the most common clinical findings in both acute and chronic illness. While many anaemias share symptoms such as fatigue and pallor, the causes, morphologies, and diagnostic approaches vary widely. This article provides a general overview of anaemia types, classifications, investigation strategies, and red flags. Detailed subtype pages (e.g. iron deficiency, thalassaemia, and haemolytic anaemias) are covered separately.
Definition
- Anaemia = decreased haemoglobin concentration
- Diagnostic thresholds (varies by sex and population):
- <130 g/L in males
- <115 g/L in females
- May also involve ↓ haematocrit (packed cell volume)
Aetiology
1. Decreased Production
- Nutritional: Iron, B12, or folate deficiency
- Marrow failure: Aplastic anaemia, myelodysplasia
- Chronic disease or inflammation
2. Blood Loss
- Acute: trauma, GI bleeding
- Chronic: menstruation, hookworm
3. Increased Destruction
- Haemolytic anaemias (autoimmune, G6PD, sickle cell)
- Inherited membrane/enzyme defects
- Microangiopathic processes (e.g. DIC, TTP)
4. Dilutional (Spurious)
- Increased plasma volume: pregnancy, fluid overload
Morphology
Cell Size (MCV Classification)
- Microcytic: MCV < 80 fL
- Normocytic: 80–100 fL
- Macrocytic: >100 fL
Staining
- Normochromic: normal haemoglobin staining
- Hypochromic: pale RBCs (usually iron deficiency)


Microscopy Patterns (Blood Film Findings)
| Pattern | Suggestive Diagnoses |
|---|---|
| Hypochromic microcytosis | Iron deficiency, thalassaemia, sideroblastic anaemia |
| Oval macrocytosis | B12 or folate deficiency |
| Microspherocytes | Autoimmune haemolysis (IgG-mediated) |
| Agglutination | Cold agglutinin disease (IgM-mediated) |
| Bite and blister cells | G6PD deficiency |
| Hypersegmented neutrophils | Megaloblastic anaemia |

Clinical Features
General Symptoms
- Fatigue
- Headache
- Exertional dyspnoea
- Angina (in those with CAD)
- Claudication
General Signs
- Pallor (mucosa, face, palms)
- Tachycardia
- Flow murmur
- Heart failure in severe cases
Specific Signs
- Koilonychia: Iron deficiency
- Glossitis: Iron or B12 deficiency
- Jaundice: Haemolysis
- Splenomegaly: Haemolytic anaemia, lymphoma
- Leg ulcers: Sickle cell
- Bone pain: Thalassaemia major, myeloma


Investigations
Key Red Cell Indices
- MCV: Mean cell volume
- MCH: Mean corpuscular haemoglobin
- MCHC: Mean corpuscular haemoglobin concentration
Other Core Tests
- Reticulocyte count: Indicates marrow response
- Blood film: Cell shape, size, inclusions
- Iron studies: Ferritin, transferrin, serum iron
- Vitamin B12 and folate
- Renal, liver, and thyroid function tests
- Coombs test (DAT/IDAT): Immune haemolysis
- Bone marrow biopsy: Myelodysplasia, aplasia
Differential Diagnosis by MCV
Microcytic (<80 fL)
- Iron deficiency
- Thalassaemia
- Chronic disease (some cases)
- Lead poisoning
- Sideroblastic anaemia
Normocytic (80–100 fL)
- Early nutritional deficiency
- Anaemia of chronic disease
- Acute blood loss
- Haemolysis
- Endocrine or renal disease
- Marrow failure
Macrocytic (>100 fL)
- B12/folate deficiency
- Alcoholism
- Liver disease
- Myelodysplasia
- Reticulocytosis




Summary – Anaemia
Anaemia is a reduction in haemoglobin concentration with numerous possible causes. A structured approach using clinical clues, red cell indices, and blood film findings can help narrow down the diagnosis. Each morphological type guides specific investigations. For a broader context, see our Blood & Haematology Overview page.